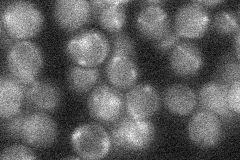
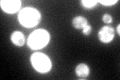

View description
Cytoplasmic and mitochondrial alanyl-tRNA synthetase, required for protein synthesis; point mutation (cdc64-1 allele) causes cell cycle arrest at G1; lethality of null mutation is functionally complemented by human homolog
Localization:
Intensity:
Fold change:
Significance:
-
C’ GFP library in SD

cytosol374.07 -
N' NOP1pr-GFP in SD

cytosol256.641 -
N' TEF2pr-mCherry in SD

missing0 -
N' NATIVEpr-GFP in SD
below threshold19.3304 -
N' TEF2pr-VC and Cyto-VN in SD

cytosol86.43 -
C’ GFP library in SD+DTT

cytosol446.551.19No -
C’ GFP library in SD+H2O2

cytosol369.190.98No -
C’ GFP library in Starvation Media
cytosol314.320.84No -
C’ GFP library on the background of Pup2-DaMP

cytosol -
C’ GFP library on the background of CCT mutant

cytosol410.0971.09627No
